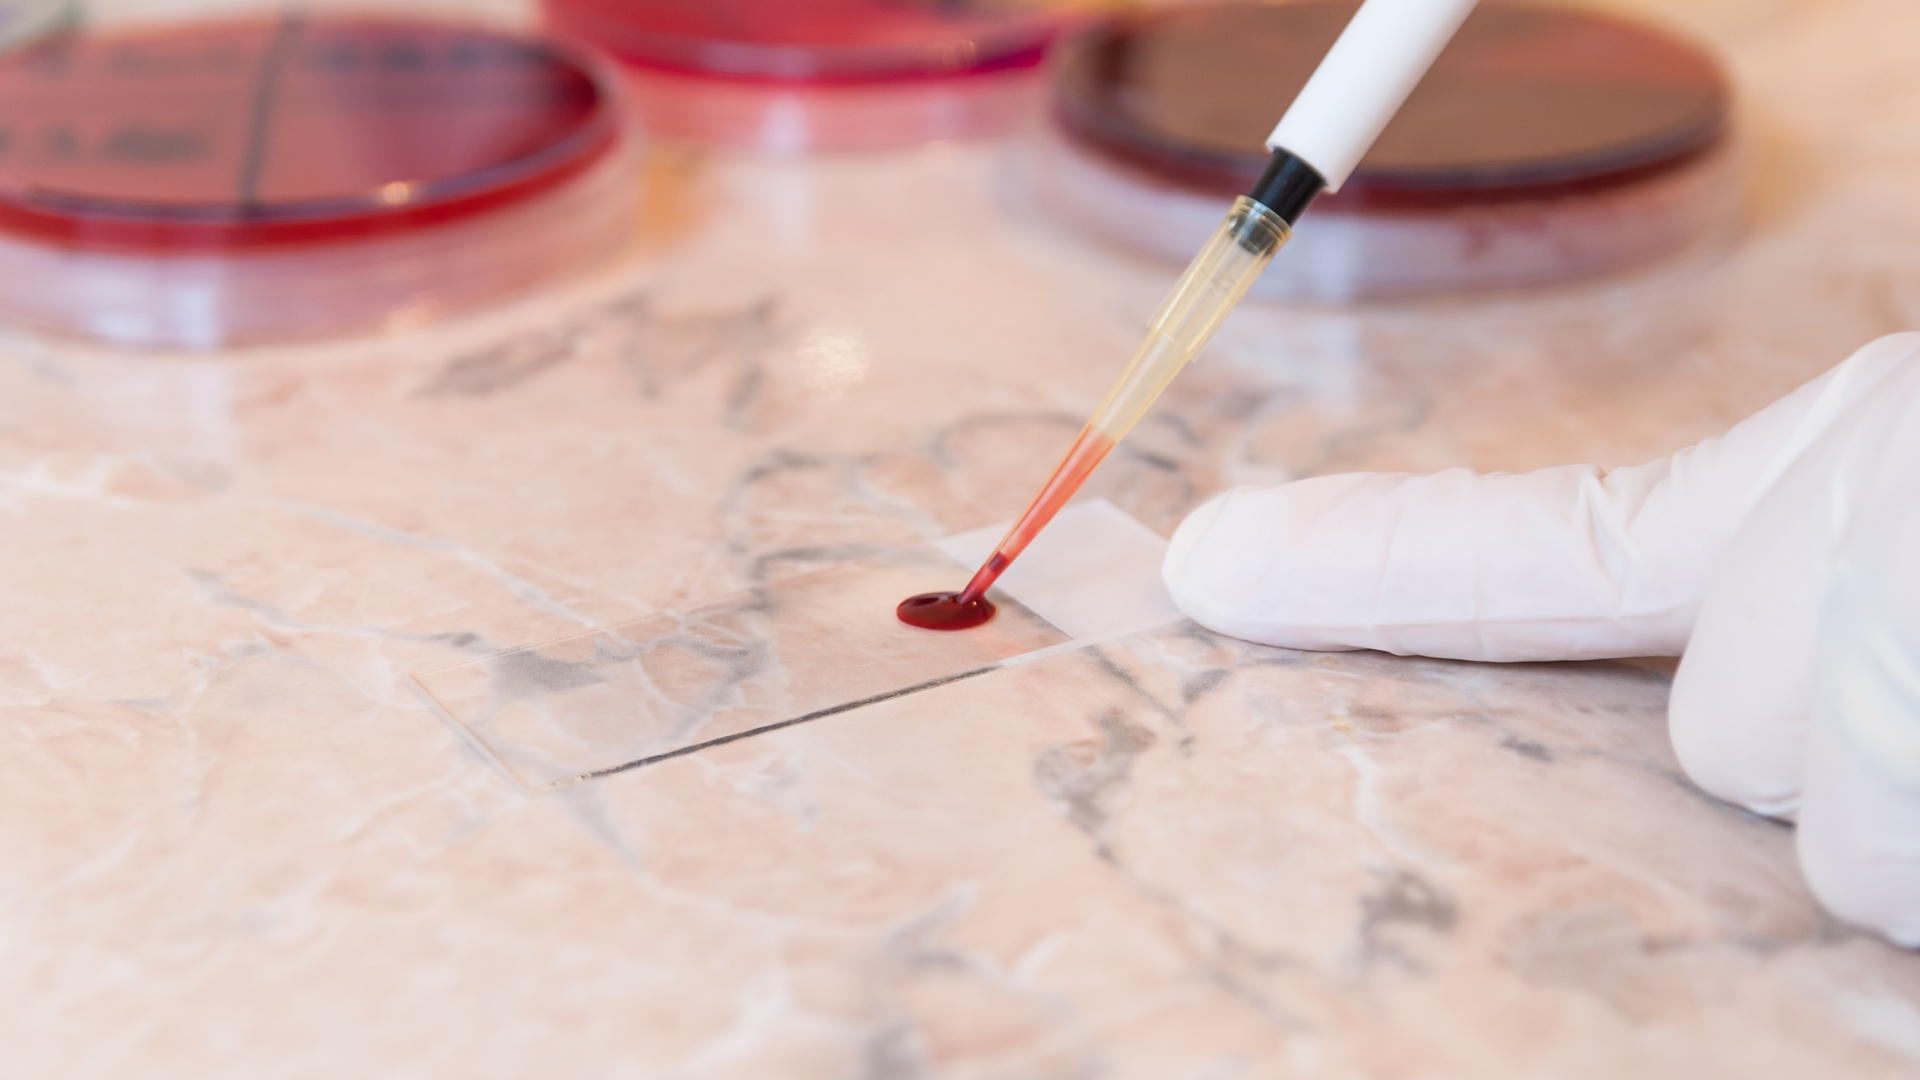

Thiếu máu là gì?
Tình trạng thiếu máu xảy ra khi lượng hồng cầu trong cơ thể bạn quá thấp. Hồng cầu đóng vai trò thiết yếu để vận chuyển oxy đến tất cả các tế bào trong cơ thể.
Trong hầu hết các trường hợp, thiếu máu có thể dễ dàng được chẩn đoán bằng các xét nghiệm máu cụ thể. Các xét nghiệm này xem xét các yếu tố như số lượng hồng cầu và tình trạng sức khỏe của các tế bào máu, sau đó dựa vào kết quả này để xác nhận chẩn đoán thiếu máu.
Những xét nghiệm máu nào có thể chẩn đoán thiếu máu?
Có một số xét nghiệm máu phổ biến có thể được sử dụng để chẩn đoán thiếu máu. Các xét nghiệm chính xác sẽ được bác sĩ chỉ định tùy thuộc vào các triệu chứng, tiền sử bệnh và kết quả của các xét nghiệm khác.
Hãy cùng xem xét kỹ hơn một số xét nghiệm máu phổ biến nhất được sử dụng để chẩn đoán thiếu máu.

Công thức máu toàn phần
Công thức máu toàn phần thường là xét nghiệm đầu tiên được chỉ định để chẩn đoán thiếu máu. Nó cũng thường được sử dụng để hỗ trợ chẩn đoán các tình trạng khác.
CBC đo các chỉ số sau trong máu của bạn:
Khi được sử dụng cho chẩn đoán bệnh thiếu máu, bác sĩ sẽ đặc biệt chú ý đến nồng độ hồng cầu và huyết sắc tố của bạn.
Một chỉ số khác thường được hiển thị trên xét nghiệm Công thức máu toàn phần có thể giúp chẩn đoán thiếu máu đó là thể tích trung bình hồng cầu (MCV). Nếu chỉ số này thấp, nó có thể chỉ ra tình trạng thiếu máu hồng cầu nhỏ chẳng hạn như thiếu sắt, và nếu chỉ số này cao, nó có thể chỉ ra tình trạng thiếu máu hồng cầu to chẳng hạn như thiếu vitamin B12.
Đọc thêm tại bài viết: Cảnh giác với bệnh thiếu máu
Xét nghiệm sắt
Đôi khi thiếu máu là do thiếu sắt. Nếu bác sĩ nghi ngờ đây có thể là nguyên nhân, họ sẽ chỉ định xét nghiệm sắt huyết thanh để đo nồng độ sắt trong máu của bạn.
Xét nghiệm sắt thường bao gồm một số chỉ số xét nghiệm sau:
Những chỉ số này có thể giúp xác định nguyên nhân gây thiếu máu là do thiếu sắt hay viêm mãn tính.
Đếm hồng cầu lưới
Đếm hồng cầu lưới để đo số lượng hồng cầu non (NRBC) trong máu của bạn. Xét nghiệm này có thể giúp bác sĩ xác định xem tủy xương của bạn có sản xuất đủ hồng cầu hay không. Xét nghiệm này rất quan trọng vì nó có thể giúp xác định nguyên nhân gây thiếu máu.
Ví dụ, nếu kết quả xét nghiệm công thức máu cho thấy bạn có số lượng hồng cầu thấp, nhưng số lượng hồng cầu lưới lại cho thấy bạn có số lượng hồng cầu non cao, điều đó có thể có nghĩa là bạn đang bị mất máu.
Ngược lại, nếu bạn có lượng hồng cầu trưởng thành và hồng cầu non thấp, điều đó có thể có nghĩa là cơ thể bạn không sản xuất đủ hồng cầu.
Đọc thêm tại bài viết: Người bị thiếu máu do thiếu Vitamin B12 nên ăn gì?
Phết máu
Phết máu là một xét nghiệm khác có thể được sử dụng để giúp xác định nguyên nhân gây thiếu máu.
Phết máu được thực hiện bằng cách nhỏ một giọt máu lên lam kính y tế. Sau đó, một dung dịch nhuộm được thêm vào lam kính, xét nghiệm này có thể giúp tìm ra bất kỳ bất thường nào về hình dạng của các tế bào máu.
Xét nghiệm này có thể đặc biệt hữu ích trong việc chẩn đoán bệnh thiếu máu hồng cầu hình liềm (đặc trưng bởi các tế bào hồng cầu hình lưỡi liềm). Nó cũng có thể hữu ích trong việc chẩn đoán một số tình trạng thiếu hụt dinh dưỡng có thể khiến hồng cầu tăng kích thước.
Các xét nghiệm khác
Nếu nghi ngờ mắc một loại thiếu máu gọi là thiếu máu tan máu (hồng cầu bị phá hủy nhanh hơn tốc độ tủy xương tạo ra), các xét nghiệm sau đây có thể được thực hiện:
Các giá trị xét nghiệm cho tình trạng thiếu máu là gì?
Các yếu tố khác nhau như tuổi tác, chủng tộc và độ cao nơi bạn sống có thể ảnh hưởng đến phạm vi được coi là bình thường cho các xét nghiệm máu về tình trạng thiếu máu khác nhau. Hãy trao đổi với bác sĩ về phạm vi được coi là bình thường đối với bạn.
Nếu kết quả xét nghiệm máu của bạn không xác nhận chẩn đoán thiếu máu, bác sĩ có thể sẽ yêu cầu các xét nghiệm bổ sung để xác định nguyên nhân gây ra các triệu chứng của bạn.
Ngoài xét nghiệm máu, bác sĩ có thể chỉ định những xét nghiệm nào để chẩn đoán thiếu máu?
Trong một số trường hợp, có thể cần thêm xét nghiệm. Điều này thường xảy ra khi bác sĩ biết bạn bị thiếu máu nhưng cần thêm thông tin để xác định nguyên nhân. Các loại xét nghiệm có thể được chỉ định bao gồm:
Triệu chứng thiếu máu là gì?

Các triệu chứng thiếu máu đôi khi diễn biến chậm. Tuy nhiên trong một số trường hợp khác, chúng có thể xuất hiện đột ngột. Nguyên nhân cơ bản của thiếu máu là một yếu tố quyết định tốc độ phát triển của các triệu chứng.
Cho dù diễn biến nhanh hay chậm, khi các triệu chứng xuất hiện, chúng thường bao gồm:
Nếu bạn gặp bất kỳ triệu chứng nào trong số này kéo dài hơn một tuần, bạn nên tới gặp bác sĩ để được chẩn đoán nguyên nhân gây ra các triệu chứng và đưa ra phác đồ điều trị phù hợp cho bạn.
Kết luận
Nếu bạn có các triệu chứng như mệt mỏi kéo dài, yếu ớt hoặc chóng mặt, bác sĩ có thể sẽ yêu cầu một hoặc nhiều loại xét nghiệm máu để xác định xem bạn có bị thiếu máu hay không. Xét nghiệm công thức máu thường là xét nghiệm đầu tiên được thực hiện để giúp chẩn đoán thiếu máu.
Các xét nghiệm máu phổ biến khác bao gồm xét nghiệm sắt, xét nghiệm hồng cầu lưới và xét nghiệm phết máu. Những xét nghiệm này cũng có thể giúp bác sĩ xác định nguyên nhân cơ bản gây thiếu máu và cách điều trị tốt nhất cho tình trạng thiếu máu của bạn.
Phòng khám chuyên khoa Dinh dưỡng VIAM (VIAM Clinic) thuộc Viện Y học ứng dụng Việt Nam tư vấn, cung cấp chế độ dinh dưỡng cá thể dành cho những người đang điều trị các bệnh mạn tính, trẻ nhẹ cân, suy dinh dưỡng, trẻ thừa cân béo phì, phụ nữ mang thai và cho con bú,… Hãy liên hệ với VIAM Clinic nếu bạn muốn có chế độ dinh dưỡng hỗ trợ điều trị và cải thiện sức khỏe TẠI ĐÂY hoặc Hotline: 0935.18.3939 / 024.3633.5678
Hiện nay, số ca ngộ độc thực phẩm trên cả nước ngày càng có dấu hiệu gia tăng, đặc biệt là do vi khuẩn Salmonella. Vậy đây là vi khuẩn như thế nào mà tỉ lệ xuất hiện này càng gia tăng? Hãy cùng VIAM tìm hiểu
Rau quả là nguồn thực phẩm quen thuộc trong mỗi bữa ăn gia đình, đặc biệt trong mùa nắng nóng. Tuy nhiên, không phải ai cũng biết cách sử dụng rau quả đúng để phát huy tối đa giá trị dinh dưỡng.
Kỳ thi học kỳ ở bậc tiểu học là cơ hội để trẻ rèn luyện kỹ năng tự học và quản lý thời gian, nhưng cũng mang lại áp lực không nhỏ từ lịch học và kỳ vọng gia đình. Nếu thiếu sự hỗ trợ đúng cách, học sinh dễ rơi vào trạng thái căng thẳng, gây ảnh hưởng tiêu cực đến sự tự tin và niềm yêu thích học tập. Viện Y học ứng dụng Việt Nam sẽ chia sẻ thông tin giúp phụ huynh nhận diện những sai lầm phổ biến để xây dựng phương pháp đồng hành hiệu quả
Duy trì các thói quen lành mạnh mỗi ngày như ăn đủ protein, ngủ đủ giấc, vận động đều đặn và kiểm soát căng thẳng giúp điều hòa chuyển hóa, tăng hiệu quả sử dụng năng lượng và hỗ trợ giảm mỡ bền vững.
Khó ngủ, mất ngủ hoặc ngủ không sâu giấc thường liên quan đến thói quen sinh hoạt và chế độ dinh dưỡng hàng ngày. Việc lựa chọn thực phẩm phù hợp có thể giúp cơ thể điều chỉnh nhịp sinh học, cải thiện chất lượng nghỉ ngơi.
Nhiều người nghĩ là cho chút muối khi luộc trứng giúp dễ bóc vỏ hơn. Thực tế, nhúm muối nhỏ là một mẹo khoa học giúp luộc trứng hoàn hảo hơn cả.
Mỗi khi mùa thi học kỳ đến gần, không khí trong nhiều gia đình lại trở nên căng thẳng hơn bao giờ hết. Với các bạn nhỏ tiểu học, lứa tuổi còn ham vui, dễ xao nhãng và chưa có kỹ năng tập trung kéo dài, kỳ thi không chỉ là thử thách với con mà còn là một cuộc chiến tâm lý đối với cả bố mẹ. Hiểu được những nỗi lo đó, Viện Y học ứng dụng Việt Nam sẽ chia sẻ thông tin để việc ôn thi học kỳ trở nên nhẹ nhàng hơn. Thay vì áp lực điểm số, sự đồng hành đúng cách của phụ huynh sẽ giúp trẻ vừa nắm vững kiến thức, vừa hình thành được thói quen tự học bền vững.
Trà xanh chứa các hoạt chất giúp bảo vệ gan hiệu quả. Tuy nhiên, nên lựa chọn lá chè tươi hái vườn hay trà khô để đạt lợi ích cao nhất mà không gây hại cho sức khỏe?